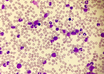

Novel treatments to prevent infections in patients with leukemia
MedicalXpress Breaking News-and-Events | Jul 28, 2021
Scientists provide new insight on how to stop transcription of cancer cells
ScienceDaily | Jul 27, 2021
Dynamic heart model mimics hemodynamic loads, advances engineered heart tissue technology
ScienceDaily | Jul 27, 2021
Those admitted on Sunday and Tuesday are more likely to develop delirium, a hospital complication
ScienceDaily | Jul 27, 2021
Investigational magnetic device shrinks glioblastoma in first-in-world human test
MedicalXpress Breaking News-and-Events | Jul 27, 2021
New understanding of cell stability with potential to improve immune cell therapies
MedicalXpress Breaking News-and-Events | Jul 26, 2021
Discovery of unknown brain-repair process could lead to new epilepsy treatments
MedicalXpress Breaking News-and-Events | Jul 26, 2021
Neuroscientists posit that brain region is a key locus of learning
ScienceDaily | Jul 26, 2021
New platform could enable personalized immunotherapy
MedicalXpress Breaking News-and-Events | Jul 26, 2021